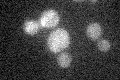
YHR065C
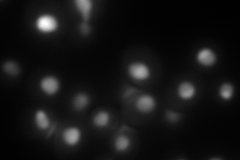
YHR065C
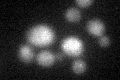
YHR065C

View description
Protein involved in rRNA processing; required for maturation of the 35S primary transcript of pre-rRNA and for cleavage leading to mature 18S rRNA; homologous to eIF-4a, which is a DEAD box RNA-dependent ATPase with helicase activity
Localization:
Intensity:
Fold change:
Significance:
-
C’ GFP library in SD
below threshold16.82 -
N' NOP1pr-GFP in SD

nucleolus151.721 -
N' TEF2pr-mCherry in SD
nucleus,nucleolus199.238 -
N' NATIVEpr-GFP in SD

nucleus,nucleolus102.326 -
N' TEF2pr-VC and Cyto-VN in SD

#N/A0 -
C’ GFP library in SD+DTT
cytosol171.01No -
C’ GFP library in SD+H2O2

cytosol16.470.97No -
C’ GFP library in Starvation Media

cytosol15.870.94No -
C’ GFP library on the background of Pup2-DaMP

below threshold -
C’ GFP library on the background of CCT mutant

below threshold18.81511.11805No
